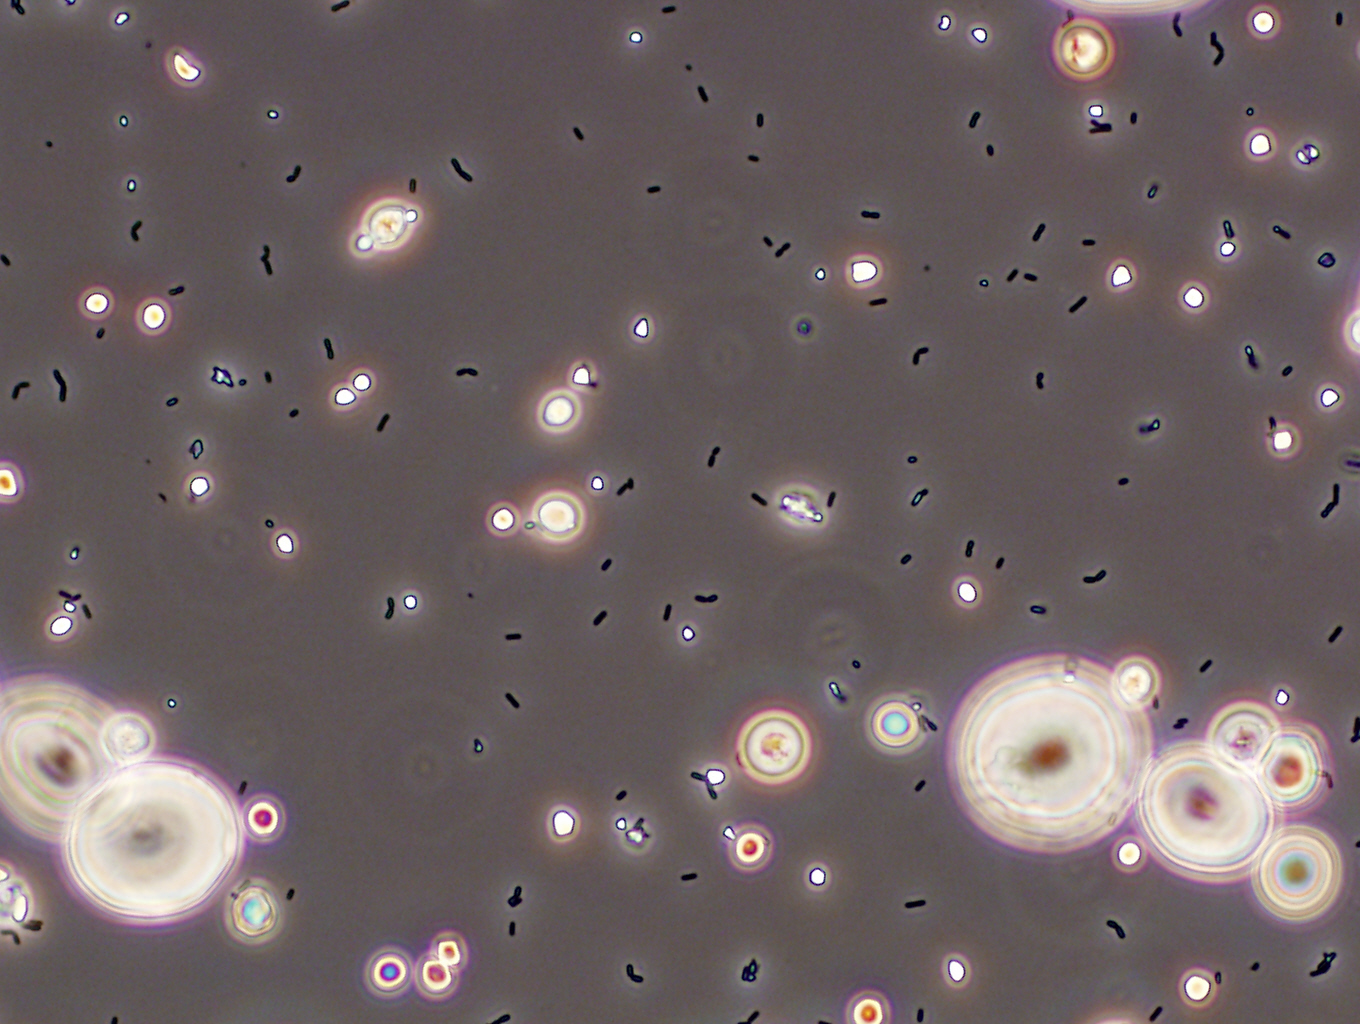

Geçtiğimiz günlerde e-postama WordPress‘den Beerader.com için yıldönümü tebriği gelmiş .. Dile kolay 1 yılımızı doldurmuşuz.. 21bin üzeri tekil tık almış blogumuz ! Tüm takipçilerimize(özellikle de geri dönüşlerde bulunup sitemizin interaktif bir platform olmasında emeği geçen sadık Beeraderlere) ve tabi ki son olarak değerli konuk yazarlarımıza MaB dolusu sevgiler 😉
Ben de bu güzel haberin şerefine yaklaşık 3 aydır içinde bulunduğum yazı orucumu bozup aylardır aklımda olan bira seyahatnamesi yazı serime başlama kararı aldım. Kemerlerinizi bağlayın ve Batı Belçika‘nın efsanevi bira evlerinde (Alvinne, St. Bernardus, Struise, Westvleteren) bir tura hazırlanın !
Önemli NOT : Bu yazıda bahsi geçen yolculuk trafiğe kapalı alanda profesyoneller tarafından gerçekleştirilmiştir…
Tarihlerden 23 Şubat 2013, yer Brüksel – Merkez İstasyonu Doğu Çıkışı (goygoycu çıkışı).. hava sıcaklığı -1 yazıyla sıfırın altında 1 … Bendeniz ve Karşıyaka‘nın gururları Oğuz Can (aka yıldırım biracılık), Evrim (aka four horseman), Atıl (aka Turboslow) uzun zamandır planladığımız bira turumuzu gerçekleştirmek üzere buluşma noktamızda son hazırlıklarımızı yapmaktayız :
Benzin Check
DSLR Check
Lens 50mm f/1.8 Check
Lens 11-16mm f/2.8 Check
Yedek SD-Kart Check
Tripod Check
Bolca Su Check
Yolda dinlemelik podcastler Check
In de Vrede’de oynamalık Belgian Beer Cards Check
Moleskine, iPad vs.. Check
Hazırız…Rasgele !
Cümleten İyi Yolculuklar !

Arabayla o yolun sonu Route 666 ama hayırlısı… – Evrim T. 2013
Evet..yolculuğu araba ile gerçekleştirme kararı almıştık. Tren hem zaman kaybı yaratcak hem de alışveriş yapmayı olanaksız kılacaktı. Bu noktada devreye tur organizatörümüz Oğuz Can girdi ve epik bir Beeraderlik örneği göstererek şoförlük yani konum itibari ile BoB olma görevini üstlendi. Kendisine bu fedakar davranışından ötürü tur ekibimiz ve beerader.com ailesi adına teşekkürleri borç bilirim 🙂
Gelelim tur planına :
|
A– Centraal Station, Brüksel |
B– Alvinne Biraevi |
|
C– St. Bernardus Biraevi
Adres: Trappistenweg 23 8978 Watou Aktivite suresi: 14:00-15:30 C-D arasi: *16km, 0h19 |
D– Struise Biraevi
Adres: Kasteelstraat 50, 8640 Oostvleteren Aktivite suresi: 16:00-16:45 D-E arasi: *7km, 0h10 |
|
E- In De Vrede Café (Westvleteren)
Adres: Donkerstraat 13, 8640 Vleteren
Aktivite Süresi : Allah ne verdiyse |
Cilt 1 : Alvinne
Alvinne mitolojıde erkekleri baştan çıkaran bir periymiş. İlk olarak evde yaptıkları biralarda bu peri logosunu kullanmışlar. 2002’de evlerinde hobi olarak başlamış bira üretim macerası. Glenn Castelein ve Davy Spiessens‘e daha sonra Marc De Keukeleire katılmış ve Alvinne triosu oluşmuş 🙂 2003’de tariflerini satıp De Graal’da ürettirmişler. 2004 de ise kendi ayakları üzerinde durup tesislerini kurmuşlar.
Alvinne bira üreticisinden öte bir butik bira deneyimi. Den Proefzolder (yani tadım çatı arası) tüm dünyadan butik biraların tadımını yapabileceğiniz bir beer geek mabedi. Ayrıca kendileri ürettikleri biraların şişlerin çoğunda detaylı bir şekilde kullanılan malzemelerden bahseden ender biraevlerinden. 3 ortakdan biri olan Glenn Castelein mekanda bira üretim dersleri veriyor ara ara. Ayrıca kendilerinin bölgenin bir diğer efsanesi Struise ile yakın ilişkileri panpalık mertebesinde. Davy aynı zamanda Struise’nin de brewmasterı. Kendilerinde ZBF gibi festivalerde (vaktim olduğunda onu da yazıcam) aynı çatı altında sunum yaparken görebilirsiniz.
Bizi mekanda Glenn Castelein ağırladı. Brewerye girdiğiniz anda sizi fıçılar ve Alvinne’nin özenle seçtiği biralardan oluşan Beershop karşılıyor. Burası bira alışverişi için cennet..Avrupa’nın bir çok yerinde bir çok butik üreticinin birasını 1-2 Euro gibi fiyatlara alabiliyorsunuz.
Daha sonra Proefzolder a geçip tadıma başladık. Ardından Glenn bizi aşağı indirip devasa(7500lt) Bourdeux şarabı fıçısında(foeder) olgunlaşmayı bekleyen Undressed‘in tadımına ve biralarıyla ilgili bir bilgilendirme seansına çağırdı. Kendisini dinlemek gerçekten çok keyifli. Öğretmenlik geçmişi olduğundan ve bira işine tutkuyla bağlandığından her şeyi en ince detayına kadar anlatan biri Glenn. Bir fıçının yanına geçip o fıçı hakkında saatlerce konuşabilecek kapasitede 🙂
Morpheus
Alvinne biralarında kendi buldukları maya kültürünü kullanmakta. Marc De Keukeleire nin ayrıştırıp evcilleştirdiği ve Aslen Fransız olan bu vahşi maya kültürünü Leuven ve Ghent’deki biracılık fakültelerine götürdüklerinde 2 tip maya türüne rastlanmış. Lactobacillus ve Saccharomyces cerevisiae .. Öncelikle ekşi biralarının yapımında kullanmışlar Morpheusu daha sonra yeteneklerini görünce tüm biralarda kullanılmaya başlanmış. Morpheus bu biraevinin imzası adeta. Glenn’e göre alkol dayanıklılığı çok yüksek(%15 ABVe kadar) ve şerbetçi otu kullanımına bağlı olarak farklı özellikler gösterebilmekte. Şerbetçi otu kullanmadıklarında(12 EBU ve altı) lactobacillus daha öne çıkıyormuş. Böylelikle ekşi bira elde ediyorlar. Bazen eğlence niyetine şerbetçi otu paletleri atıyoruz biralarımıza ve beer geeklerden tahmin yürütmelerini istiyoruz diyor Glenn.. Morpheus Leuven üniversitesinin maya kitaplığında -70de saklanıyor ve bir gurur kaynağı Alvinne için..
Alvinne çatısı altında 30 cıvarı fıçı bulundurmakta.. Bu Fransız Monbazillac (tatlı beyaz şarap), Amerikan/Fransız meşesi, Normandy Calvados(brandy), Burgundy şarabı, Malaga şarabı (Moscatel üzümü), Glenrothes/İskoçya viski fıçıları ve Kentucky bourbon fıçılarını içeren çok özel bir kolleksiyon.
Glenn özenle topladığı fıçılarını büyük bir tutku ile anlattı bize. Hatta buram buram ceviz kokan Malaga fıçısını zorla koklattı bize 🙂 Fıçılar bahsettiğim gibi özenle toplanıyor. Şarap fıçılarında şarabın bekleme süresi önemli. Bekledikçe tanin fıçıda kalmak yerine şaraba karışıyor. Tanin demek biranızı başka biralarla karıştırıp dengelemeniz demek ki bu her zaman çok kolay olmuyor.
Tadım Notları
Beer Geek Wedding in Londen City
Evet Londen.. Epic typo failure gibi düşünmüş olabilirsiniz ama Londranın Flamancası bu 🙂
Tipi : Ekşi Ale
Bölgesi : Moen / Belçika
Alkol Oranı : %8 ABV alkol oranı
Önerilen Sıcaklık : 8-10 Derece
Bardak Tipi : Tulip veya konyak
Raf Ömrü: 5 yıl
– Alvinne’nin İngiltere’den dostları Paul ve Simone’nin (Mes ve Sim) düğünü için yapılmış bir bira bu. Hatta üstünde düğün davetiyesi de var. Aynı düğün için Struise’de Black Damnation VI Messy’i yapmış.(Black Mes’in %39luk çılgın versiyonu). Onun dışında Beer Hunters Nasty Suicide Imperial Stout’da bu düğün için üretilmiş biralardan. Sanırsam De Molen’da birşeyler yapmış. Yani özetle bu bira için ülkemizde yıllardır üretilenden daha çok çeşit bira üretilmiş ve emek harcanmış 🙂
– Viski fıçısında bekletilmiş Morpheus Dark ile Kerasus 2010‘un karışımı bu bira. Schaarbek vişneleri kullanılmış. Vişneler çekirdekleri ile atıldığından bu cevizimsi bir etki veriyor biramıza.
– Koyukırmızı erik kompostosuna benzer bir rengi var biramızın. Hafif karamel ince bir köpüğü var. Lacing yok denecek kadar az. Köpük kararsız ve zamanla sönüyor.
– Aromada bolca meşe var, vanilya ve vişne. Oldukça ekşi ve maya hissedilir derece de. Brett (a.k.a at etkisi) oldukça az.
– Lezzet aromayı takip eder nitelikte. Çok hoş ekşi, asidik ve uzun bir bitiş.
– Gövde hafif sayılır. Yumuşak bir gazlılık var. Taze lambiği andırıyor.
– Genel olarak türe çok uygun. Dolayısıyla benim gibi bu stilin fanatiklerinin çok seveceği buram buram emek kokan ve çok özel bir bira.
Diğer beeraderlerin yorumları ve Puanlama
Benim puanım 9 / 10
Ratebeer : Overall : 92, Style : 48
Beeradvocate : BA Score : NA , The Bros : NA
Undressed
Tipi : Ekşi Ale / Flaman Alesi
Bölgesi : Moen / Belçika
Alkol Oranı : %6,9 ABV alkol oranı
Önerilen Sıcaklık : 8-10 Derece
Bardak Tipi : Tulip veya konyak
Raf Ömrü: 4 yıl
– Mekanda Undressed’in Bordeaux şarabı fıçısı görmüş versiyonunu içtik ama ne yazık ki notunu almamışım 😦 O yüzden evde yaptığım düz versiyonunun tadım notlarını paylaşcam.
– Şişe üstündeki veriler ve içindekiler: 0 EBU (demekki lactobacillus ön planda), Morpheus kullanılmış, 5 çeşit malt, 178EBC, kristal şeker
– Koyu kırmızı bir şarap görünümünde. Köpük neredeyse yok. Biraz sallayıp yuvarlarsanız hızlıca köpürüp sönüyor.
– Şarap mantarı, sirke, az da olsa karamelize şeker, az ağaç, biraz islilik ve tütün aromada var..
– Şalgam suyu tadında.. hafif tuzluluk var (astringent?).. bitiş uzun ve az da olsa yapışkan.
– Gövde orta, gazlılık az ve yumuşak.
– Genel olarak fazla keskin bir bira. Ya blending yapılmalı yada uzunca fıçı görmeli.
– Bol yağlı bir peynir ile denedim mesela gayet güzel gitti.
Diğer beeraderlerin yorumları ve Puanlama
Benim puanım 7 / 10
Ratebeer : Overall : 70, Style : 25
Beeradvocate : BA Score : 85, The Bros : NA
Mekandan aldığımız diğer biraları kilerde bekletiyorum 🙂 O yüzden incelemelerimiz şimdilik bu kadar. Daha gidecek çok yolumuz içecek çok biramız var. Bir sonraki Seyâhatnâme-i Meşrubat yazımızda görüşmek üzere.
Bu arada instagram hesabımızda güzel güzel bira fotoğrafları çekip paylaşmaya devam ediyoruz. Yurtdışından ilgili büyük ama şimdilik yerel beeraderleri göremedik pek 😦 Tekrar hatırlatmak istedim duymayan olduysa 😉
Instagram hesabımız için : http://instagram.com/beeradercom
Mekanda çektiğimiz diğer birkaç resim..

Selamlar,
Öncelikle 1. yılınız hayırlı olsun. Umarım ilgi ve şevkin artarak devam eder ve biz de bu güzel yazıları Türkçe olarak okumaya ve yeni şeyler keşfetmeye devam edelim.
Yazı harika, yokluktan mıdır bilinmez (gerçi siz Belikça’da varlık içindesiniz artık) bu tarz bira seyahatnamelerini bizim gibi Türkçe bloggerlardan çıkıyor 🙂
Yorumlara geçecek olursak; Beer cards olayı çok ilgili çekti, sitesine baktım amaingilizce versiyonuna ulaşamadım. Nasıl ulaşabilirim? Bira Koleksiyonerleri için çok güzel bir ürün..
L,stee efsane Biraevleri var, bunlar hakkındaki yorumlar yazılar geldikçe yapılacak, ilk biraevini bu yazı ile öğrenmiş oldum. Biralarına ulaşmak bizler için hayal ama yazı kesinlikle merak uyandırıcı ve not ettirici. Belçika seyahatlerim artarsa neden olmasın?
Ev biralcılığından hallice kısmı içimde fırtınalar koparıyor ama ev biracılığından hallice olup kendi mayaları ile bira yapmaları tezatlıkları ve bu ülkede Bira Kültürünün ne seviyede olduğunu gösteriyor. Helal olsun! Devlet bizi desteklemiyor kardeşim, yoksa biz de yaparız.. 🙂
O düğünü ve bu arakdaşların bu bira evleri ile dostluklarını çok merak ettim. Efsane bir hikayeymiş,ayrı bir yazının konusı bile olabilir. Biz de bir dostumuzun düğünü için özel bira düşünmüştük ama olanaksızlıklar, taşıma saklama vs yapılmadı malesef..
Fıçıda olgunlaştırma Cantillon gibi eskilerin yanında son dönemde tüm bira-evlerinin uyguladığı bir olgunlaştıma yöntemine dönüşmeye başladı. Şarap gibi,viski gibi fıçının kattıkları çok değişken ve çok önemli. Süre,fıçı ve amaç dikkate alınmalı. Bira yükselen birdeğer ve bu gibi uygulamalar ile hem fiyatını hem de alıcı kitlesindeki gelir seviyesinin yukarıya çekilmesi kaçınılmaz olabilir..
Bira tadımlarına değinemedim bile, daha fazla uzatmayayım yazı içinde yazı gibi olacak ama her paragrafı hakkında özel muhabbet edilebilecek bu yazı ve harika rota için tekrar teşekkürler.
Oğuz Can aynı iyiliği tanışma gecemizde bana da yapmış ve otele kadar bırakmıştı. Ben de teşekkürlerimi sunayım. Böyle bir gezide şoförlük büyük fedaakarlık 😉
BiraAtolyesi Selamlar
Değerli yorumların için çok teşekkürler.
Beercards’ın sitesi ilginç bir şekilde açılmıyor. Ben Mechelen’da hediyelik eşya satan bir yerden almıştım. Bir daha önünden geçerken senin içinde alır Türkiye’ye giden birileri ile ulaştırırım sana.( İtiraz yok 🙂 )
Valla sizin biraatolyesi olarak şartlara inat yaptıklarınızı düşündükçe.. kanlıca yoğurt maya kültüründen ayrıştırılmış bir hakiki anadolu lactosu hikayesi hiç uzak gözükmüyor aslında 🙂
Dediğin gibi düğün olayı efsane. Düğünden daha çok bira festivali olmuş gibi.
Artık BiraAtolyesi’nden de Çoruh Saplı meşesi fıçısında bekletilmiş bir barrel project bekliyoruz 😉
Selam,
Açıkçası BeerCards olayının bu şekle dönüşmesinde korkarak yorum yapmıştım. İtiraz edeceğim ama engellenmiş. Neyse, bir şekilde ödeşiriz. 🙂
Kendi mayamızı bilmem ama TR’de şarapçılık olduğı için fıçıda bekletme olayını düşünmedik değil. Çok zor bir işlem de değil ama beklemek zor zanaat. Ayrıca daha önce belirttiğim sebeplerden ötürü atölyemiz durmuş durumda. Yeni bir lokasyon belirleyene kadar bu gibi düşünceler hep hayallerde kalacak.
Yazının 2. bölümünü merakla bekliyoruz.
Görüşmek üzere..
Geri bildirim: Seyâhatnâme-i Meşrubat – Cilt 2 : St. Bernardus | Beerader.com